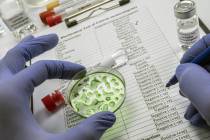

Cleveland Clinic Nevada said it will offer concierge medicine and executive health services at a new clinical location in the southwest Las Vegas Valley.
Health
If the high-stakes presidential race is causing existential dread or rifts with loved ones, there’s no need to white-knuckle through it.
Researchers have picked up on this trend and are racing to find out why it is occurring within this ethnically diverse group.
A new study looked at eight nations where people live the longest, with the U.S. not even ranking in the top 40.
The cereal aisle at the grocery story is lined on both sides with options. But not all of these morning meals are equal.
In a recent study, researchers found a possible link between behavioral and physical health.
Old pals Toni Braxton and Cedric the Entertainer took a break from rehearsals for “Love & Laughter” at The Cosmo to share their good life tips.
Left untreated, obstructive sleep apnea is linked to daytime sleepiness and an increased risk of anxiety, diabetes, hypertension and stroke.
A switch taking effect Jan. 1 will make prescription drugs more affordable for Americans on Medicare.
Nearly 10 million pounds of meat and chicken products were recalled because of listeria, impacting seven of the top 10 grocery-selling chains in the United States.
Historic numbers of Americans are living on their own as they age, and it can have profound health consequences.
Experts tell us that a robust immune system is one of the most potent weapons we have against viral illnesses such as influenza and COVID.
The Aging Wellness Expo is more than just an event — it’s an opportunity to shape a more inclusive, age-positive future.
We asked Dr. Graham King, a high-risk breast consultant, to share the top 10 questions about breast cancer that he hears from patients.
“I don’t know what to expect when I step onto a new set. But I choose to turn that fear into excitement,” the two-time Oscar winner says.
Michele Klimke has been a dedicated medical dosimetrist for forty years and joined the Comprehensive Cancer Centers of Nevada (Comprehensive) team in 2007. With extensive experience in developing and managing radiation plans for patients undergoing cancer treatment, she never anticipated finding herself on the other side of the machine. After undergoing a routine mammogram, Michele […]
In our daily lives, twelve feet is a familiar measure – the height of an extension ladder, the top of a basketball backboard, and the width of a lane on freeways across America. However, when it comes to an emergency responder or a driver in distress on the side of the road, twelve feet can […]
Dental implants are quickly becoming the preferred solution for replacing missing teeth, whether you need to replace one, several, or all your teeth, depending on the condition of your oral health. Implants are known for their durability, functionality, and natural appearance. In this blog, guided by tips from 4M Dental Implant Centers, leaders in the […]
Did you know? The updated flu and COVID-19 vaccinations for 2024-2025 are now available at Southern Nevada Health District clinics. You can receive both vaccines at the same time. The Health District and the Centers for Disease Control and Prevention (CDC) recommend that everyone eligible get their updated vaccinations to help protect against severe illness […]